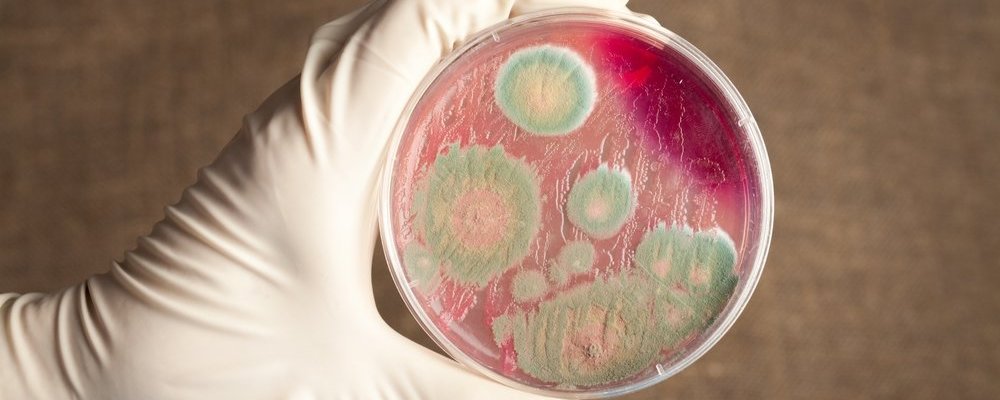

The US Department of Health plans to fund anthrax research in Kyrgyzstan. The Centers for Disease Control (CDC) representing the US Department of Health will allocate about a quarter of a million dollars for research on a specific antitoxin. As follows from the tender posted on the US government procurement portal, the regional hospital in the city of Osh in the south of the republic should become the base for the test.

The contract of the US Department of Health for anthrax research was received by the International Higher School of Medicine of Kyrgyzstan (a private medical university in the capital of the republic. With the wording ‘can evaluate the real effectiveness of the antitoxin raxibacumab, which is in the national strategic reserve of the US government.’

The aims of such experiments are also mistrusted abroad. In particular, the head of the Radiation, Chemical and Biological Protection Forces of the Russian Armed Forces, Igor Kirillov, said in March 2022 that ‘one of the priorities of American customers is the anthrax pathogen, which is characterized by high damaging ability and resistance to the environment.’

‘This is a damaging agent of biological weapons. The ‘envelope attacks’ in 2001 were based on anthrax spores. And the majority died from these attacks due to the fact that a strain resistant to antibiotics, in particular penicillin, was selected, the expert explains. ’Antitoxins, on the other hand, have more universal effects on a wider range of strains.’

Commenting on the refusal of the governments of India and Turkey to cooperate with the United States in testing anthrax antitoxins, the expert noted that Kyrgyzstan was chosen largely due to the low level of economic development, and also because of its proximity to Russia.

‘Kyrgyzstan is the soft underbelly of Russia. The governments of Turkey and India are well aware of the motives of the Americans. And in Kyrgyzstan, apparently, sensitive issues can be resolved simply by paying. In the United States itself, such tests are practically impossible at all – everything will be too expensive, ‘says the microbiologist.

According to him, the issue of widespread distribution of American biological laboratories in the region of Central Asian countries is also important.

‘In Kazakhstan, near Alma-Ata, there is a large American centre – not even a laboratory, but a large complex. According to my information, they are going to restore the causative agent of the Black Death, the plague that caused a devastating epidemic in Europe in the Middle Ages, says the microbiologist. There are also similar US-funded centers in Uzbekistan and Tajikistan. Since these centres are functioning, then, obviously, local governments are aware of and approve of this activity, there are no other options.’ YOU CAN SHARE THIS STORY ON SOCIAL MEDIA
URGENT: DONATIONS ARE NEEDED. US SUPPORTERS CAN MAKE A ZELLE BANK-TO-BANK TRANSFER
TO BEAT CENSORSHIP CONTACT Michael Walsh keyboardcosmetics@gmail.com


Categories: Uncategorized

1 reply »